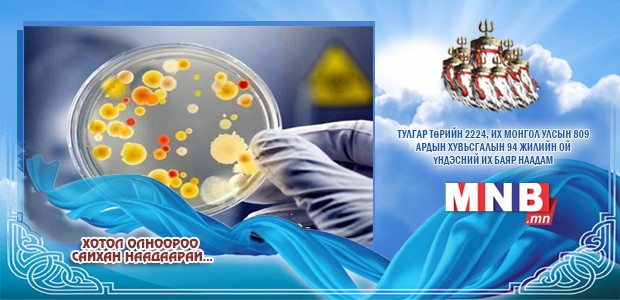

Эрүүл мэндийн сайдын тушаалын дагуу Тарваган тахлын эсрэг дархлаажуулалтыг долоодугаар сарын гурав дахь долоо хоног буюу энэ сарын 15-наас 19-ны хооронд улсын хэмжээнд зохион байгуулахаар төлөвлөж байна.
Дархлаажуулалтыг явуулахаар Казахстан улсад үйлдвэрлэсэн тарвага тахлын эсрэг 29.800 хүн тун вакциныг 17 аймаг, есөн дүүргийн ЗӨСТ, болон Эрүүл мэндийн байгууллагуудад хүргүүлээд байгаа аж. Дархлаажуулалтад тарваган тахлын голомтот нутгийн хүн ам, малчид, эрүүл мэндийн байгууллага, онцгой байдал, мэргэжлийн хяналт, хууль сахиулах байгууллагын ажилтнууд зэрэг эрсдэлт бүлгийн хүн ам хамрагдах болно.
| Орон даяар тарваган тахлын вакцин хийнэ | ||
| Үзсэн: 1216 | Mongolian National Broadcaster |


 Үндэсний телевиз
Үндэсний телевиз





















































































































 Лханаагийн Мөнхтөр
Лханаагийн Мөнхтөр

 Р.Слава
Р.Слава

 Б.Цоожчулуунцэцэг
Б.Цоожчулуунцэцэг





Сэтгэгдэл бичих:
АНХААРУУЛГА: Уншигчдын бичсэн сэтгэгдэлд MNB.mn хариуцлага хүлээхгүй болно. ТА сэтгэгдэл бичихдээ хууль зүйн болон ёс суртахууны хэм хэмжээг хүндэтгэнэ үү. Хэм хэмжээг зөрчсөн сэтгэгдэлийг админ устгах эрхтэй. Сэтгэгдэлтэй холбоотой санал гомдолыг 70127055 утсаар хүлээн авна.